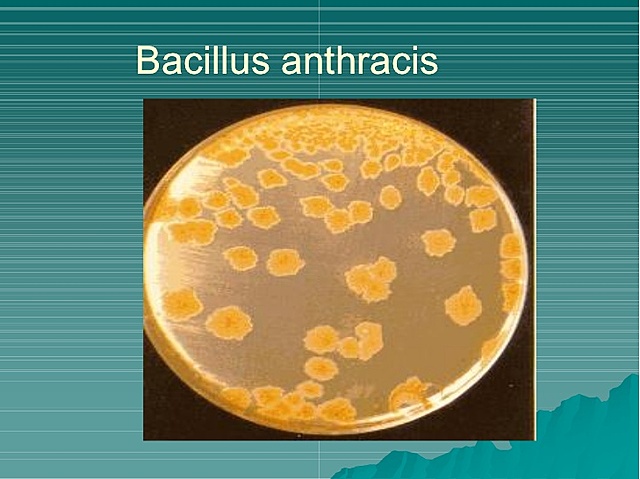
Bacillus anthracis

-
Tucídides, el gran historiador de la guerra del Peloponeso quien describió una peste en Atenas, escribió en 430 a.C., que sólo quienes se habían recuperado de la peste podían cuidar de los enfermos porque no contraerían la enfermedad una segunda vez.
-
Lady Mary Wortley Montagu, la esposa del embajador británico en Constantinopla, observó los efectos positivos de la variolación sobre la población turca nativa, e hizo que la técnica se practicara en sus propios hijos
-
El médico inglés Edward Jenner más tarde hizo un avance gigante en el desarrollo deliberado de inmunidad, nuevamente
dirigido hacia la viruela, intrigado por el hecho de que las ordeñadoras que habían contraído la enfermedad leve viruela
del ganado vacuno eran inmunes después a la mucho más grave
viruela, Jenner razonó que introducir líquido de una pústula de viruela vacuna en personas podría protegerlas contra la viruela. -
Pasteur vacunó por vez primera a un grupo de ovejas con la bacteria del ántrax (carbunco) (Bacillus anthracis) que fue atenuada mediante tratamiento con calor
-
Pasteur administró su primera vacuna a un ser humano, un niño que había sido mordido repetidas veces por un perro rabioso el niño, Joseph Meister, fue inoculado con una serie de preparaciones de virus de la rabia atenuados
-
Von Behring y Kitasato demostraron que el suero el componente líquido, no celular, recuperado a partir de sangre coagulada de animales previamente inmunizados con difteria podía transferir el estado inmune a animales no inmunizados.
-
Jules Bordet en el Pasteur Institute expandió el concepto de inmunidad más allá de las enfermedades infecciosas, al demostrar que sustancias no patogénicas, como eritrocitos de otras especies, también podían servir como antígenos.
-
La concepción más temprana de la teoría selectiva se remonta a Paul Ehrlich en 1900. En un intento por explicar el origen de los anticuerpos séricos, Ehrlich propuso que las células en la sangre expresaban diversos receptores, que llamó receptores de cadena lateral, que podían unirse a agentes infecciosos y desactivarlos.
-
Charles Richet, quien intentó inmunizar perros contra las toxinas de un tipo de medusa; él y su colega Paul Portier observaron que los perros expuestos a dosis subletales de la toxina reaccionaron casi al instante, y de modo mortal, a un desafío posterior con cantidades incluso diminutas de la misma toxina
-
Con la facilidad actual para realizar viajes alrededor del mundo, el surgimiento de una cepa pandémica de gripe podría superar con mucho la devastación desencadenada por la pandemia de gripe de 1918, que originó más de 50 millones de muertes.
-
avance importante en el tratamiento de enfermedades infecciosas se logró cuando se introdujeron los primeros antibióticos durante el decenio de 1920-1929. Los antibióticos son agentes químicos diseñados para destruir ciertos tipos de bacterias
-
Esto empezó con la sugerencia de que el timerosal, un aditivo a base de mercurio usado para inhibir el crecimiento bacteriano en algunas preparaciones de vacunas desde el decenio de 1930-1939.
-
la dotación de resistencia a agentes patógenos por medio de transferencia de anticuerpos desde un donante inmunizado hacia un receptor no inmunizado, se usó para prevenir sarampión y hepatitis A, o para modificar su evolución.
-
Se otorgó un Premio Nobel a Karl Landsteiner (antes mencionado por sus contribuciones al concepto de la especificidad inmunitaria) por el descubrimiento de los grupos sanguíneos ABO, un hallazgo que permitió la práctica segura de transfusiones de sangre
-
Merrill Chase, quien laboraba en The Rockefeller Institute, logró conferir inmunidad contra la tuberculosis al transferir leucocitos entre cobayos. Hasta ese punto, los intentos por desarrollar una vacuna o terapia con anticuerposeficaz contra la tuberculosis habían fracasado. De este modo,la demostración de Chase ayudó a reavivar el interés por la inmunidad celular.
-
se identificó al linfocito como el tipo de célula del cual dependen las inmunidades tanto celular como humoral.
-
Por medio de la información obtenida por F. Macfarlane Burnet, Niels
Jerne y David Talmadge, este modelo se refinó hacia una hipótesis que llegó a conocerse como la teoría de la selección clonal.Esta hipótesis se ha refinado y ahora se acepta como un paradigma subyacente de la inmunología moderna. -
Una consecuencia de generar receptores de reconocimiento al azar es que algunos podrían reconocer al huésped y dirigirse contra el mismo. A fin de que esta estrategia funcione con eficacia, el sistema inmunitario debe de algún modo evitar reconocer y destruir accidentalmente tejidos del huésped. Este principio, que se fundamenta en la discriminación de lo propio/extraño, se llama tolerancia, otro dato característico de la respuesta inmunitaria.
-
Susumu Tonegawa, que en aquel entonces laboraba en The Basel Institute for Immunology en Suiza, descubrió el mecanismo molecular que está detrás de los eventos de recombinación del dna que generan receptores de célula B y anticuerpos, lo cual fue un
verdadero punto de inflexión en el entendimiento de la inmunología; -
En 1977 se observó el último caso conocido de viruela adquirida de modo natural en Somalia; esta temida enfermedad se erradicó mediante la aplicación universal de una vacuna similar a la usada por Jenner alrededor de 1790.
-
G. Snell, J. Dausset y B. Benacerraf fueron reconocidos por el descubrimiento del complejo principal de histocompatibilidad (mhc), se trata de los antígenos tisulares que difieren más entre individuos no idénticos genéticamente y, así, son uno de los blancos primarios del rechazo inmunitario de tejidos trasplantados
Plan projects on a visual timeline
Map milestones, phases, deadlines, and key events in one place so the sequence is easier to see and share. Timetoast is a timeline maker for work, school, research, and stories.